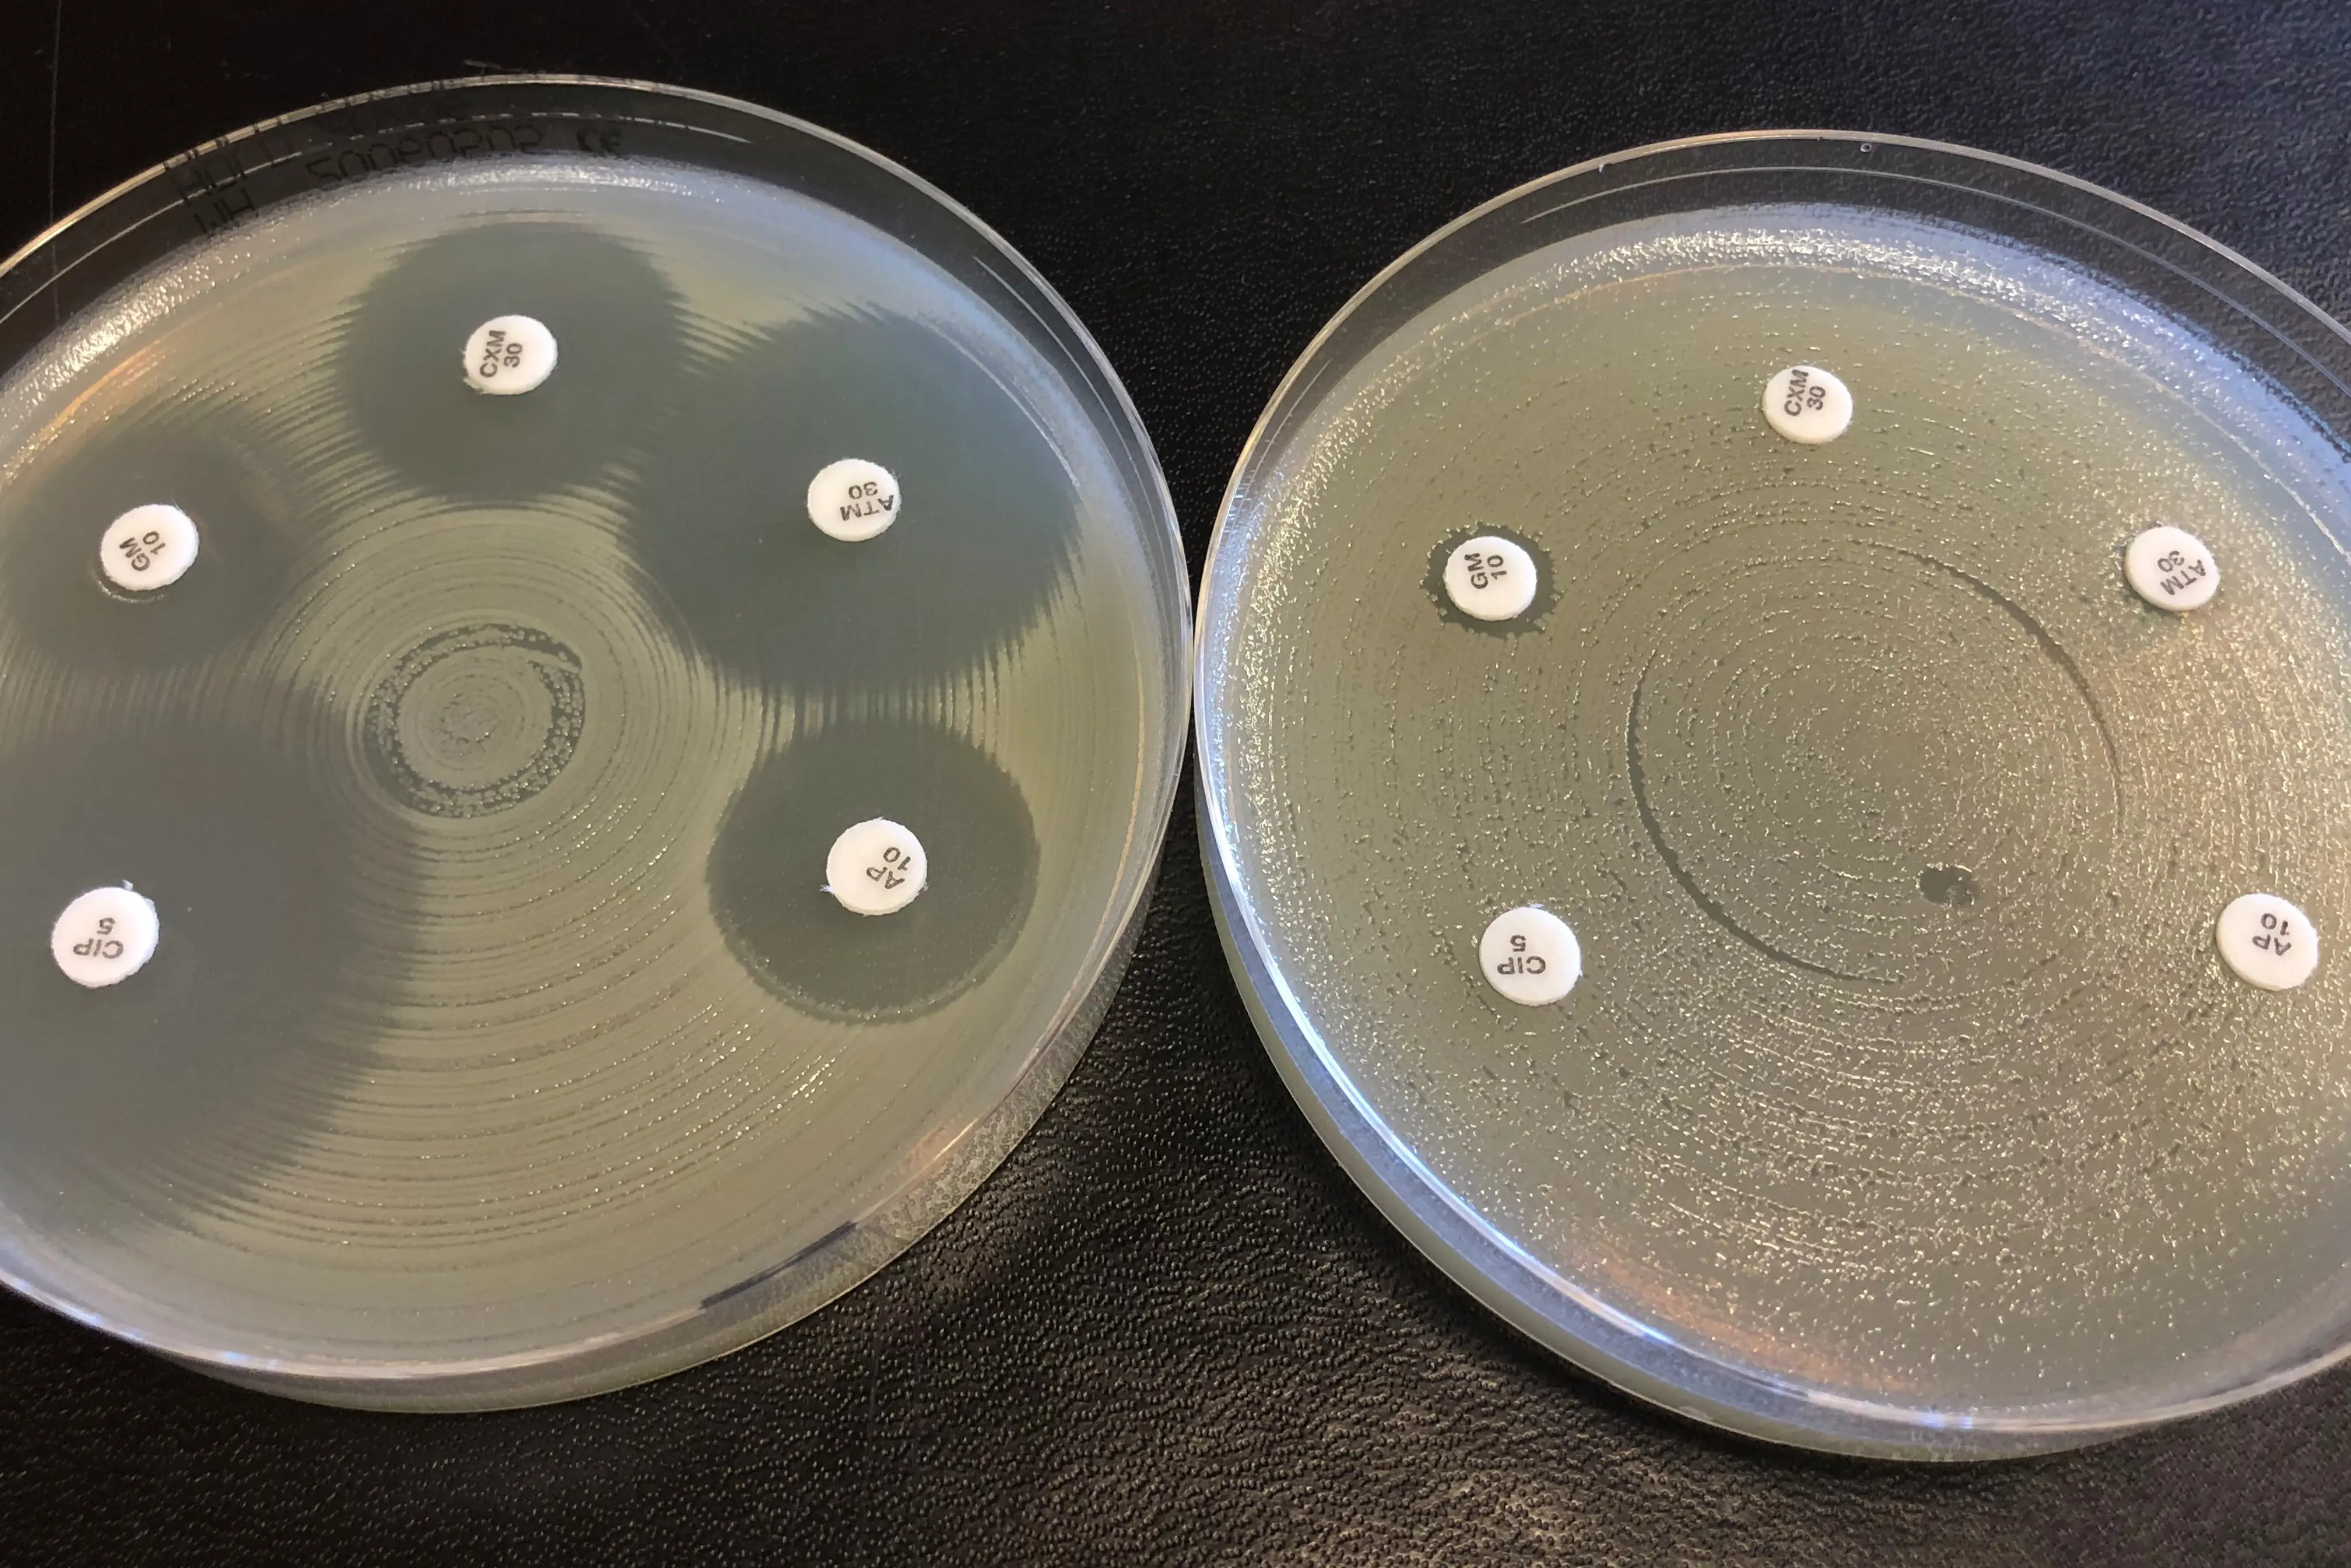
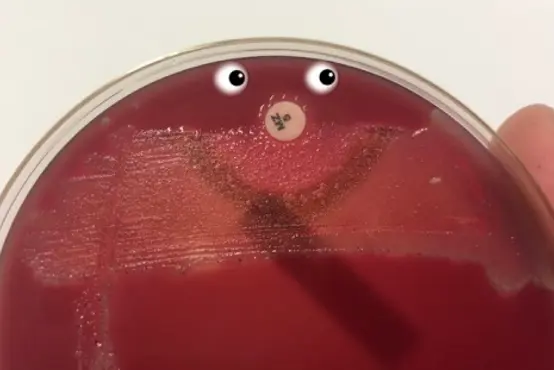

Ekspertsykehuset
Bakterier kan være følsomme - men har de følelser?
Det er ikke uvanlig at vi menneskeliggjør bakteriene vi omgir oss med og som en gang iblant forårsaker infeksjoner. Særlig i kampen mot antibiotikaresistens brukes metaforer som snille bakterier, slemme bakterier, superbakterier og så videre, vi mikrobiologer snakker ofte om følsomhetskategorisering av bakterier. Men kan de virkelig føle?

Tekst av: Jørgen Vildershøj Bjørnholt, overlege og førsteamanuensis og Karianne Wiger Gammelsrud, overlege. Avdeling for mikrobiologi OUS. Foto: Privat og Shutterstock.
Hva mener vi med følsomhetskategorisering?
La oss nå ta en ting om gangen. Når vi snakker om følsomhetskategorisering av bakterier, tenker vi ikke på menneskelige følelser, men på følsomhet for antibiotika. Altså er følsomhetskategorisering mer eller mindre synonymt med resistensbestemmelse, hvor vi i laboratoriet måler om en gitt bakterie er følsom eller resistent for et gitt antibiotikum.

Jørgen Vildershøj Bjørnholt, overlege og førsteamanuensis og Karianne Wiger Gammelsrud, overlege. Avdeling for mikrobiologi OUS. Foto: Privat.
Antibiotika kan hemme bakteriers vekst, og i noen tilfelle også drepe bakterien. Et godt antibiotikum hemmer eller dreper bakteriene når de blir eksponert for konsentrasjoner som er toksiske for bakteriene, men ikke er farlige for verten (menneske eller dyr) som har en infeksjon.
Prinsippet for følsomhetskategorisering er at vi sammenholder testing i laboratoriet med om vi kan behandle infeksjonen mikroben har fremkalt (terapeutisk suksess). Det er ulike måter å utføre resistenstesting på i laboratoriet, og felles for metodene er at bakterien utsettes for antibiotika i ulike konsentrasjoner hvorpå vi ser om bakterien har blitt hemmet (følsom mikrobe) eller klarer å vokse (resistent mikrobe). En mye benyttet metode er lappediffusjon illustrert ved bildet under.
Foto: Privat, KWG.
Bildet viser resistensbestemmelse av to ulike bakterier ved «lappediffusjon». De små, runde lappene inneholder ulike antibiotika i standardiserte konsentrasjoner. Når vi ser en stor oppklarende sone uten bakterievekst rundt antibiotika-lappen, er det sannsynlig følsomhet (venstre), mens bakterievekst tett inntil lappen indikerer resistens (høyre).
Det brukes nøyaktig linjal-måling av sonene som sammenliknes med standardiserte tabeller for de ulike bakterie-antibiotika-kombinasjonene før bakteriens endelige følsomhetskategorisering angis som S (følsom standard dose), I (følsom, økt eksponering) eller R (resistent uansett dosering).
SIR – nå betyr både «S» og «I» at bakterien er følsom!
Tidligere betød I kategoriseringen «Intermediær», men denne betydningen er fra 2019 endret slik at I nå betyr Følsom, økt eksponering. Det vil si at hvis man kan øke eksponeringen av bakterien for det antimikrobielle middelet ved å tilpasse dosering eller ved oppkonsentrering på infeksjonsstedet, er dette en effektiv behandling. Når bakterien blir kategorisert som S: Følsom, standarddose kan infeksjonen behandles med standard doser, og når bakterien kategoriseres som R: Resistent kan aktuelle middel ikke brukes uansett dosering.
Det er altså viktig å lese svaret fra mikrobiologen nøye og ha kunnskap om dosering av antibiotika om en skal gi best mulig behandling.
Men har bakterier egentlig følelser?
Så tilbake til spørsmålet om bakteriene har følelser. Det er vanlig å definere at følelser forutsetter et nervesystem med nevroner – noe som bakteriene definitivt ikke har.
MEN, vi har lenge visst at bakterier kan oppfatte og tilpasse seg sine omgivelser. Et typisk eksempel er tilgang til næringsstoffer og sporulering (når en bakterie innkapsler seg og går i dvale) og når den germinerer (våkner til live igjen etter dvale).
Dette er kompliserte prosesser, og det synes som om at bakterien både kan føle og huske (1). Skeptikeren vil si: «Men dette er jo bare kjemi!». Ikke et dårlig argument, men bakterier kan faktisk også registrere berøring. Denne evnen er svært viktig når bakterien skal finne en overflate å slå seg ned på når den fremkaller en infeksjon (2).
Så har bakterier følelser? Njaah – sannsynligvis ikke, men de kan føle! Og akkurat den forståelsen kan kanskje være en del av veien frem når vi skal utvikle nye behandlingsstrategier for antibiotikaresistente bakterier.
Foto: Privat, KWG.
Referanser:
1. PLoS One. 2008; 3(2): e1700. Published online 2008 Feb 27. doi: 10.1371/journal.pone.0001700
2. Science. 2017: Vol. 358, Issue 6362, pp. 531-534 DOI: 10.1126/science.aan5353
Nyttig lesing:
Brukerhåndbok i mikrobiologi (OUS)
Tidsskriftet for Den norske legeforening:
- Ny S-I-R kategoriserig: https://tidsskriftet.no/2019/09/debatt/valg-av-antibiotika-viktig-endring-i-provesvar-fra-mikrobiologen
- Dosering (inkludert PK/PD): https://tidsskriftet.no/2020/09/klinisk-oversikt/antibiotikadosering-teori-og-praksis
Les flere blogginnlegg fra Ekspertsykehuset!